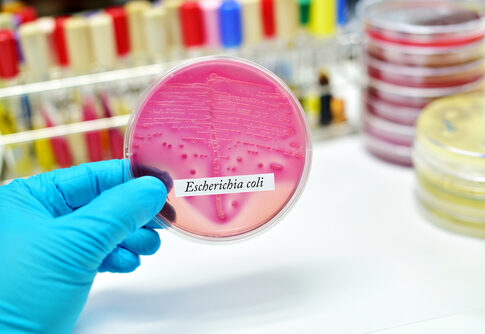
.

A “Class I” USDA recall on nearly 23,000 pounds of ground beef is a blunt reminder that the most basic job of government—protecting public health—still depends on constant vigilance, not slogans.
What the USDA Recall Covers—and Why “Class I” Matters
FSIS announced a Class I recall—its most serious category—for raw ground beef produced by CS Beef Packers, LLC, after possible E. coli O145 contamination was detected through routine testing at a downstream customer. Class I is reserved for situations where exposure carries a risk of serious adverse health consequences or death. The total volume cited in reports ranges from 22,912 pounds to roughly 23,000 pounds, a difference that appears to be rounding.
Ground beef recall: 23,000 pounds over E. coli contamination risk | Fox Business https://t.co/TpIlpCMenW
— LARRY ,EXECUTIVE MBA (@STERLING9798) February 13, 2026
Reports indicate the affected products were produced on January 14, 2026, at the company’s Kuna, Idaho facility and were intended for foodservice—not grocery store shelves. The recall focuses on specific 10-pound packages of coarse- and fine-ground beef, including products sold under the Fire River Farms brand, with detailed case codes and a “Use/Freeze By” date of February 4, 2026. Foodservice operators were advised to check their inventory and discard or return any affected items.
Why the Distribution Details Should Reassure Families—But Not Restaurants
Published coverage emphasizes that distribution went to foodservice channels in California, Idaho, and Oregon, which reduces the likelihood that typical households have this exact product in their refrigerators. That distinction matters because it narrows the immediate exposure risk for families who buy their meat at retail. It also places responsibility on distributors and restaurants, where a single lot can be portioned into many servings before anyone realizes there is a problem.
Restaurant kitchens and cafeterias also face a tougher reality: they often handle high volumes, multiple suppliers, and fast turnover—conditions that can magnify the impact of any contamination event. Even with responsible operators, a recalled product can end up in a freezer and remain there until the next menu cycle. The practical takeaway is simple: if you run foodservice operations, recall alerts are not “paperwork.” They are a liability and a safety issue that must be acted on immediately.
Can't find this on X, so: "The @USDA announced a #recall of 23,000 lbs of ground #beef tonight. The meat was processed 4 weeks ago. The type of E. coli found in the meat can cause kidney failure and death. This is a Class 1 recall, the most serious type." via @NassMeryl, MD.… pic.twitter.com/SyfChPmO9X
— Jennifer Virden (@Jennifer4Austin) February 12, 2026
What We Know About the Detection—and What We Don’t
The recall was triggered by routine FSIS testing conducted at a downstream customer, not by a confirmed illness outbreak. CS Beef Packers stated that internal testing for each lot produced “acceptable results,” and that the issue was identified because the government’s testing detected E. coli O145 after the product left the plant. Based on the available reporting, the exact date of that downstream test has not been publicly specified.
This limited timeline is important when evaluating blame versus process. The available facts support the conclusion that regulators detected a pathogen signal and took steps to prevent potential harm, but they do not establish where or how contamination occurred. That uncertainty is exactly why conservatives typically prefer transparent, measurable standards over political theater: the public deserves clear chain-of-custody facts, not assumptions. For now, the documentation indicates that the recall is precautionary and that no illnesses have been confirmed.
The Health Risk: E. coli O145 and Who Is Most Vulnerable
E. coli O145 is a Shiga toxin-producing strain that can cause severe symptoms, including bloody diarrhea and vomiting, with reported onset ranging from two to eight days after exposure (often three to four days). Reporting also notes that children under five, older adults, and people with weakened immune systems face a higher risk of hemolytic uremic syndrome (HUS). This serious complication can damage the kidneys and become life-threatening.
Food safety guidance highlighted in coverage includes cooking ground beef to an internal temperature of 160°F and maintaining clean handling practices to avoid cross-contamination. That advice may sound basic, but it is the difference between “no illnesses reported” and a real outbreak. In a country where the cost of living already squeezes families, the last thing anyone needs is a preventable foodborne illness caused by sloppy handling or ignored recall notices.
Sources:
Enormous ground beef recall issued over deadly E. coli contamination risk across three states
Ground beef recall states ecoli